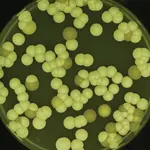

Medical myths persist because tradition often outweighs evidence in clinical practice. Many clinicians continue to practice based on anecdotal experience and how they were trained, relying on familiar patterns with many failing to critically appraise new evidence as it emerges.1-3 Early studies, often limited in scope or misinterpreted, can become entrenched in medical teaching, reinforcing outdated concepts. Fear-based prescribing also plays a role, where some may favor “safer” or more aggressive regimens, even when evidence does not support superiority. Over time, these factors can create a cycle where dogma is perpetuated, despite robust evidence challenging its validity. Breaking this cycle requires deliberate efforts to replace tradition with data-driven practice and the emphasis of nuanced decision-making over simplistic rules.1-3
The commonly taught belief that bactericidal antibiotics are always superior to bacteriostatic agents is a classic example that exemplifies this phenomenon, and the classification of agents as “cidal” or “static” has long shaped prescribing practices.4-6 According to the conventional definition, bactericidal antibiotics kill the organism through their action, where bacteriostatic antibiotics inhibit bacterial growth through their action.4,6,7 Although it may seem intuitive that “killing” a pathogen should always be better than “not killing” it, this oversimplification ignores the complexity of the management of patients with infections, where outcomes may be influenced by other pharmacologic factors, the pathogen itself, host immunity, the site of infection, and the clinical context.4-7
Therefore, the primary objective of this review is to examine the in vitro definitions of bactericidal versus bacteriostatic antibiotics, their limitations, and the clinical evidence surrounding the two. Given that most of the clinical data involve immunocompetent patients and exclude endocarditis and infections of the central nervous system, these populations and infections are not the focus of this review.4
Microbiological Definitions of Cidal and Static Antibiotics
Although most clinicians use simplistic definitions to define whether an agent is considered bactericidal or bacteriostatic, the long-standing microbiological definition for these classifications relies on 2 key parameters: the minimum inhibitory concentration (MIC) and minimum bactericidal concentration (MBC).4,6,7 The MIC represents the lowest concentration of an antimicrobial that inhibits visible growth of an organism after 24 hours of incubation, whereas the MBC is the lowest concentration that reduces the bacterial density by 1,000-fold at 24 hours. By the formal definition, an antibiotic is considered bactericidal if the MBC/MIC ratio is less than or equal to 4, whereas it is otherwise labeled as bacteriostatic if the MBC/MIC ratio is greater than 4 (Figure 1).4,6,7
Translational Challenges of In Vitro Cidal and Static Classifications
It is critical to recognize that findings derived from basic science, while foundational, do not invariably translate into clinically meaningful outcomes.4,6,7 MIC and MBC values provide standardized measures of antimicrobial activity under controlled in vitro conditions; however, it is essential to acknowledge that these experimental systems differ fundamentally from the complex physiologic environment of human patients. Many in vitro experiments ignore the dynamic and variable interplay of antimicrobial concentrations, host immunity, and infection site variability. Also, these laboratory experiments commonly occur in very specific, predefined experimental conditions such as a fixed bacterial inoculum, standardized media, a controlled temperature, and timed incubation (eg, 24 hours), none of which reflect human physiology. These experiments may also assume constant antibiotic exposure, aerobic conditions, and exponential bacterial growth, where infections often involve fluctuating antimicrobial levels, sites of infection that may lack adequate oxygenation, and organisms in the stationary growth phase.6-8
Drugs that are classically considered bactericidal are not exclusively bactericidal. Cidality for a particular antibiotic can depend on many things such as the specific organism, the bacterial inoculum, antibiotic concentrations, and the aforementioned experimental conditions (Figure 2).6,7 As some examples, linezolid is classically considered bacteriostatic against gram-positive organisms (ie, staphylococci) but has demonstrated cidality against other gram-positive isolates (ie, streptococci).6,7,9 Although beta-lactams are classically considered bactericidal, they lose their ability to kill as effectively at higher inocula.10,11 Of note, all static drugs have the ability to kill but require higher concentrations in relation to their MICs at the site of infection.4,6,7 These in vitro nuances underscore the potential inadequacy of firm cidal and static labels in predicting clinical outcomes.
Clinical Data
Of the various clinical studies published comparing the outcomes of bactericidal versus bacteriostatic agents, one of the most notable is the systematic review published by Wald-Dickler et al.4 In this evaluation, the authors sought to determine whether clinical data were available to validate the dogma that cidal agents are more efficacious than static agents. A comprehensive search was conducted between January 1985 and September 2017 for randomized controlled trials (RCTs) comparing the efficacy of bactericidal versus bacteriostatic agents. Retrospective and/or observational studies and RCTs comparing bactericidal with bactericidal agents and bacteriostatic versus bacteriostatic agents were excluded.4
The authors identified 56 RCTs that compared the efficacy of cidal and static agents in patients with bacterial infections.4 Specifically, most studies evaluated the efficacy of cidal versus static agents against skin and soft tissue infections (n=19) and pneumonia (n=19), while other infections included those of an intraabdominal origin, typhoid fever/salmonellosis, sexually transmitted diseases, and plague. Of the 56 included RCTs, 49 (87.5%) found no significant difference in efficacy between the cidal versus static agents. In fact, 6 trials (10.7%) found that bacteriostatic agents were more efficacious than bactericidal agents, and only 1 study (1.9%) found that a bactericidal agent led to higher cure rates than the bacteriostatic agent.4
When critically evaluating this one RCT, the investigators assessed the comparison of tigecycline (static) (100-mg loading dose followed by 50 mg every 12 hours) with imipenem-cilastatin (cidal) for the treatment of hospital-acquired pneumonia.12 In patients with ventilator-associated pneumonia, tigecycline led to lower cure rates than imipenem-cilastatin; however, tigecycline was noninferior to imipenem-cilastatin in patients with non–ventilator-associated pneumonia.12 Pharmacokinetic/pharmacodynamic (PK/PD) analyses determined that the tigecycline dose used in the initial trial was not adequate enough to hit PK/PD targets in patients with ventilator-associated pneumonia.13-15 When a subsequent trial doubled the dose of tigecycline (200-mg loading dose followed by 100 mg every 12 hours), tigecycline had numerically higher rates of clinical cure/response compared with imipenem-cilastatin for the treatment of hospital-acquired pneumonia, including ventilator-associated pneumonia.16 Of note, other published clinical studies have confirmed no consistent advantage of bactericidal over bacteriostatic therapy for many infectious types.17,18
Pharmacologic and Clinical Principles to Prioritize
Although MIC and MBC values are accurate measures of the efficacy of antibiotics in vitro, the optimal antibiotic dose depends on PK/PD indexes to measure in vivo efficacy.4,6,7 Thus, some would argue that a more meaningful prediction of clinical success hinges on optimized PK/PD rather than the cidal and static classification of a particular antibiotic. As examples, key PK/PD indexes include the time above the MIC (eg, beta-lactams), the area under the concentration-time curve to MIC ratio (eg, vancomycin), and the concentration maximum to the MIC ratio (eg, aminoglycosides), and these parameters guide therapeutic dosing strategies to maximize bacterial killing (Figure 3). Antibiotic penetration at the site of the infection is also paramount to effectiveness.19 A theoretically “cidal” agent is ineffective if it fails to reach therapeutic concentrations at the site of infection. Furthermore, clinical considerations such as adequate source control and timing of antibiotic therapy remain essential determinants of clinical success. Thus, antibiotic selection should prioritize achieving PK/PD targets, ensuring adequate tissue penetration, and consider patient-specific factors to optimize clinical outcomes.4,6,7
Conclusion
The debate over the superiority of bactericidal to bacteriostatic antibiotics in all scenarios reflects a challenge in medicine with the persistence of tradition over evidence.4,6,7 While in vitro constructs such as the MIC and MBC provide useful microbiological benchmarks, they fail to capture the complexity of infections in the real-world setting, where host factors and PK/PD often govern outcomes. Clinical trials have consistently shown no significant differences in efficacy of cidal and static agents for many infections, and other factors such as optimized PK/PD parameters, adequate tissue penetration, and timely source control should be prioritized to optimize outcomes. Clinicians should shift from dogma-driven prescribing to evidence-based, individualized decision-making, prioritizing pharmacologic principles and patient-specific factors over in vitro labels.4,6,7
References
- Phillips MC, Davar K, Freling S, et al. Practicing with intent: how to teach an old dogma new tricks. Clin Infect Dis. 2025;81(3):410-413.
- McCreary EK, Johnson MD, Jones TM, et al. Antibiotic myths for the infectious diseases clinician. Clin Infect Dis. 2023;77(8):1120-1125.
- Kaufman E, Lagu T, Hannon NS, et al. Mythmaking in medical education and medical practice. Eur J Intern Med. 2013;24(3):222-226.
- Wald-Dickler N, Holtom P, Spellberg B. Busting the myth of “static vs cidal”: a systemic literature review. Clin Infect Dis. 2018;66(9):1470-1474.
- Spellberg B, Wald-Dickler N, Holtom P, et al. Static vs. cidal: it’s not complex; it’s simply incorrect. Antimicrob Agents Chemother. 2025;69(8):e0051325.
- Ishak A, Mazonakis N, Spernovasilis N, et al. Bactericidal versus bacteriostatic antibacterials: clinical significance, differences and synergistic potential in clinical practice. J Antimicrob Chemother. 2025;80(1):1-17.
- Pankey GA, Sabath LD. Clinical relevance of bacteriostatic versus bactericidal mechanisms of action in the treatment of Gram-positive bacterial infections. Clin Infect Dis. 2004;38(6):864-870.
- Bergogne-Berezin E. Interactions among antibiotics, bacteria and the human immune system: the clinical relevance of in vitro testing. J Chemother. 1997;9(suppl 1):109-115.
- Zurenko GE, Yagi BH, Schaadt RD, et al. In vitro activities of U-100592 and U-100766, novel oxazolidinone antibacterial agents. Antimicrob Agents Chemother. 1996;40(4):839-845.
- Eagle H, Musselman AD. The rate of bactericidal action of penicillin in vitro as a function of its concentration, and its paradoxically reduced activity at high concentrations against certain organisms. J Exp Med. 1948;88(1):99-131.
- Shah PM. Paradoxical effect of antibiotics. I. The “Eagle effect.” J Antimicrob Chemother. 1982;10(4):259-260.
- Freire AT, Melnyk V, Kim MJ, et al. Comparison of tigecycline with imipenem/cilastatin for the treatment of hospital-acquired pneumonia. Diagn Microbiol Infect Dis. 2010;68(2):140-151.
- Bhavnani SM, Rubino CM, Hammel JP, et al. Pharmacological and patient-specific response determinants in patients with hospital-acquired pneumonia treated with tigecycline. Antimicrob Agents Chemother. 2012;56(2):1065-1072.
- Burkhardt O, Rauch K, Kaever V, et al. Tigecycline possibly underdosed for the treatment of pneumonia: a pharmacokinetic viewpoint. Int J Antimicrob Agents. 2009;34(1):101-102.
- Ambrose PG, Bhavnani SM, Ellis-Grosse EJ, et al. Pharmacokinetic-pharmacodynamic considerations in the design of hospital-acquired or ventilator-associated bacterial pneumonia studies: look before you leap! Clin Infect Dis. 2010;51(suppl 1):S103-S110.
- Ramirez J, Dartois N, Gandjini H, et al. Randomized phase 2 trial to evaluate the clinical efficacy of two high-dosage tigecycline regimens versus imipenem-cilastatin for treatment of hospital-acquired pneumonia. Antimicrob Agents Chemother. 2013;57(4):1756-1762.
- Nemeth J, Oesch G, Kuster SP. Bacteriostatic versus bactericidal antibiotics for patients with serious bacterial infections: systematic review and meta-analysis. J Antimicrob Chemother. 2015;70(2):382-395.
- Saleem N, Ryckaert F, Snow TAC, et al. Mortality and clinical cure rates for pneumonia: a systematic review, meta-analysis, and trial sequential analysis of randomized control trials comparing bactericidal and bacteriostatic antibiotic treatments. Clin Microbiol Infect. 2022;28(7):936-945.
- Onufrak NJ, Forrest A, Gonzalez D. Pharmacokinetic and pharmacodynamic principles of anti-infective dosing. Clin Ther. 2016;38(9):1930-1947.
Copyright © 2026 McMahon Publishing, 545 West 45th Street, New York, NY 10036. Printed in the USA. All rights reserved, including the right of reproduction, in whole or in part, in any form.

Download to read this article in PDF document:![]() Beyond the Labels: In Vitro and Clinical Realities Of the Bactericidal Versus Bacteriostatic Debate
Beyond the Labels: In Vitro and Clinical Realities Of the Bactericidal Versus Bacteriostatic Debate
This article is from the February 2026 print issue.